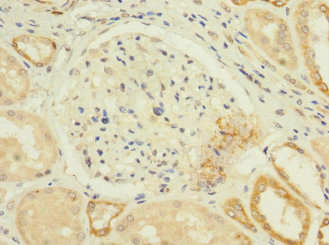

CACNA1H Antibody
-
中文名稱:CACNA1H兔多克隆抗體
-
貨號:CSB-PA004404ESR1HU
-
規(guī)格:¥440
-
圖片:
-
其他:
產(chǎn)品詳情
-
產(chǎn)品名稱:Rabbit anti-Homo sapiens (Human) CACNA1H Polyclonal antibody
-
Uniprot No.:
-
基因名:
-
別名:Alpha1 3.2 antibody; Alpha13.2 antibody; CAC1H_HUMAN antibody; CACNA 1H antibody; CACNA1 H antibody; CACNA1 HB antibody; Cacna1h antibody; CACNA1HB antibody; Calcium channel alpha13.2 subunit antibody; Calcium channel voltage dependent T type alpha 1H subunit antibody; Calcium channel; voltage-dependent; T type; alpha 1Hb subunit antibody; Cav 3.2 antibody; Cav T.2 antibody; Cav3.2 antibody; CavT.2 antibody; EIG 6 antibody; EIG6 antibody; Low voltage activated calcium channel alpha 13.2 subunit antibody; Low voltage activated calcium channel alpha1 3.2 subunit antibody; Low-voltage-activated calcium channel alpha1 3.2 subunit antibody; MNCb 1209 antibody; T type Cav3.2 antibody; Voltage dependent t type calcium channel alpha 1H subunit antibody; Voltage gated calcium channel alpha subunit Cav 3.2 antibody; Voltage gated calcium channel alpha subunit Cav T.2 antibody; Voltage gated calcium channel alpha subunit Cav3.2 antibody; Voltage gated calcium channel alpha subunit CavT.2 antibody; Voltage-dependent T-type calcium channel subunit alpha-1H antibody; Voltage-gated calcium channel subunit alpha Cav3.2 antibody
-
宿主:Rabbit
-
反應(yīng)種屬:Human
-
免疫原:Recombinant Human Voltage-dependent T-type calcium channel subunit alpha-1H protein (260-360AA)
-
免疫原種屬:Homo sapiens (Human)
-
標記方式:Non-conjugated
-
克隆類型:Polyclonal
-
抗體亞型:IgG
-
純化方式:Antigen Affinity Purified
-
濃度:It differs from different batches. Please contact us to confirm it.
-
保存緩沖液:PBS with 0.02% sodium azide, 50% glycerol, pH7.3.
-
產(chǎn)品提供形式:Liquid
-
應(yīng)用范圍:ELISA, IHC, IF
-
推薦稀釋比:
Application Recommended Dilution IHC 1:20-1:200 IF 1:50-1:200 -
Protocols:
-
儲存條件:Upon receipt, store at -20°C or -80°C. Avoid repeated freeze.
-
貨期:Basically, we can dispatch the products out in 1-3 working days after receiving your orders. Delivery time maybe differs from different purchasing way or location, please kindly consult your local distributors for specific delivery time.
-
用途:For Research Use Only. Not for use in diagnostic or therapeutic procedures.
相關(guān)產(chǎn)品
靶點詳情
-
功能:Voltage-sensitive calcium channel that gives rise to T-type calcium currents. T-type calcium channels belong to the 'low-voltage activated (LVA)' group. A particularity of this type of channel is an opening at quite negative potentials, and a voltage-dependent inactivation. T-type channels serve pacemaking functions in both central neurons and cardiac nodal cells and support calcium signaling in secretory cells and vascular smooth muscle. They may also be involved in the modulation of firing patterns of neurons. In the adrenal zona glomerulosa, participates in the signaling pathway leading to aldosterone production in response to either AGT/angiotensin II, or hyperkalemia.
-
基因功能參考文獻:
- These findings reveal spectrin (alpha/beta) / ankyrin B cytoskeletal and signaling proteins as key regulators of T-type calcium channels expressed in the nervous system. PMID: 29720258
- In colonic biopsies, the Cav3.2 mRNA level was significantly higher in the irritable bowel syndrome group compared to controls. PMID: 27196538
- Here we show that T-type channels Cav3.1 and Cav3.2 are present in the lung and PASMCs from iPAH patients and control subjects. The blockade of T-type channels by the specific blocker, TTA-A2, prevents cell cycle progression and PASMCs growth PMID: 28655554
- Our data establish Stac1 as an important modulator of T-type channel expression and provide new insights into the molecular mechanisms underlying the trafficking of T-type channels to the plasma membrane. PMID: 27149520
- CACNA1H variant is associated with differential antiepileptic drug response in childhood absence epilepsy. PMID: 28165634
- There is a direct link between CACNA1H(M1549V) mutation and an increased aldosterone production. This suggests that calcium channel blockers may be beneficial in the treatment of a subset of patients with primary aldosteronism. PMID: 27258646
- CACNA1H might be a susceptibility gene predisposing to PA with different phenotypic presentations, opening new perspectives for genetic diagnosis and management of patients with PA. PMID: 27729216
- modulation of N-linked glycosylation of hCav3.2 channels may play an important physiological role PMID: 26745591
- heterozygous mutations identified in a pediatric patient with chronic pain and absence seizures result in loss of channel function, with significantly smaller current densities across a wide range of voltages when co-expressed in tsA-201 cells. PMID: 26706850
- Study revealed no association between the 15 tagSNPs of CACNA1A, 1C, and 1H and antiepileptic drug efficacy in the Chinese Han epileptic population; the TAGAA haplotype of CACNA1A may be a risk factor for drug resistance PMID: 26216687
- Cav3.2 channels are highly phosphorylated in the mammalian brain and establish phosphorylation as an important mechanism involved in the dynamic regulation of Cav3.2 channel gating properties PMID: 26483470
- Recurrent gain of function mutation in calcium channel CACNA1H causes early-onset hypertension with primary aldosteronism. PMID: 25907736
- reveal an unexpected role of CaV3.2 channels in regulating NMDA-R-mediated transmission and a novel epileptogenic mechanism for human childhood absence epilepsy PMID: 26220996
- The I-II loop of the Cav3.2 protein inhibits neuronal Cav3.1 and Cav3.2 channels. PMID: 25931121
- C456S mutation leads to substantially increased excitability of cultured neurons due to increased spontaneous firing rate. PMID: 24277868
- N-linked glycosylation of Cav3.2 not only controls surface expression. PMID: 23503728
- Data indicate that endogenous/exogenous hydrogen sulfide regulates function of T-type Ca(2+) channel Cav3.2 expressed in HEK293 cells PMID: 24508802
- It plays pivotal roles in processing of pain signals.(review) PMID: 23903007
- Both Asp residues critically control the biophysical properties of Ca(v)3.2, including relative permeability between Ba2+ and Ca2+, voltage dependency of channel activation, Cd2+ blocking sensitivity, and pH effects, in distinctive ways. PMID: 23849427
- Cav3.2 is differently expressed in normal pleura and malignant pleural mesothelioma PMID: 22564432
- Data suggest a pathway in which thioredoxin (Trx) acts as a tonic, endogenous regulator of Cav3.2 channels, while heme oxygenase-1 (HO-1)-derived carbon dioxide (CO) disrupts this regulation, causing channel inhibition. PMID: 23671274
- Results indicate that the S4-S5 and S6 helices from adjacent domains are energetically coupled during the activation of a low voltage-gated T-type CaV3.2 channel. PMID: 23970551
- A novel Cav3-KCa1.1 signaling complex has been identified where Cav3-mediated calcium entry enables KCa1.1 activation over a wide range of membrane potentials. PMID: 23626738
- Cav3.2 regulates calcineurin/NFAT pathway through both the Ca(2+) influx and calcineurin binding PMID: 23669360
- Our results support the notion that ion channel autoimmunity might at least partially contribute to HaNDL pathogenesis and occurrence of neurological symptoms. PMID: 23111027
- The abnormal mRNA expressions of T-type channel alpha1H and alpha1G may be one of the causes of declined semen quality and infertility in varicocele patients. PMID: 22574369
- ZnT-1 enhances the activity of CaV3.1 and CaV3.2 via activation of Ras-ERK signaling pathways in the plasma membrane. PMID: 22572848
- Cav3.2 channels were expressed at the membrane of large portions of cells, with no likely relation to Cav3.1 expression or apoptosis. PMID: 22469755
- A Ca(v)3.2/syntaxin-1A signaling complex controls T-type channel activity and low-threshold exocytosis. PMID: 22130660
- Data showed expression of L-type (Ca(v) 1.2), P/Q-type (Ca(v) 2.1), and T-type subtype (Ca(v) 3.1 and Ca(v) 3.2) voltage-gated calcium channels (Ca(v)s) in renal artery and dissected intrarenal blood vessels from nephrectomies. PMID: 21788606
- The function of T-type Ca(2+) channels is important for the proliferation of human ovarian cancer cells. PMID: 21438841
- Review: I-II loops of T-channels play critical roles in the trafficking and gating of these channels. This loop contains an intracellular gating brake that is essential to their ability open after small depolarizations of the membrane. PMID: 21099341
- Ca(V)3.2 alternative splicing generates significant T-type Ca channel structural and functional diversity with potential implications relevant to cardiac developmental and pathophysiological states PMID: 20699644
- Present evidence that N2O-based inhibition of Cav3.2 channels is mediated by free radical signalling and results in analgesia. PMID: 21059758
- functional modulation of the Ca(v)3.2 channels by Cav-3 is important for understanding the compartmentalized regulation of Ca(2+) signaling during normal and pathological processes. PMID: 21084288
- T-type calcium channel gene-CACNA1H might be a susceptibility gene to childhood absence epilepsy. PMID: 15833171
- Review discusses mutations of the Cav3.2 isoform (CACNA1H gene) that enhance channel activity and their association with idiopathic generalized epilepsies, whereas mutations that disrupt its activity are associated with autism spectrum disorders. PMID: 19903827
- We conclude that low voltage activated voltage-operated Ca(2+) channels are expressed in cells of the human male germ line. PMID: 11751928
- characterization in terms of activation and inactivation properties as well as cation permeability PMID: 14529577
- Ca(v)3.2 has a role in calcium influx during physiological activation and mutations may be causative in the propensity for seizures in patients with childhood absence epilepsy PMID: 14729682
- recombinant low voltage-activated T-type Ca channels exhibit a small, though clearly evident, window T-type Ca(2)(+) current which is also present in native channels from different neuronal types--REVIEW PMID: 15498803
- CACNA1H is a susceptibility gene in complex idiopathic generalized epilepsy PMID: 15852375
- Data indicate that Domain IV/S4 of Ca(v)3.2 is an activation domain and is not involved in inactivation from the open state. PMID: 16133267
- Cloning and calcium channel characteristics of Cav3.2 isoforms. PMID: 16301824
- His-191 in the S3-S4 loop is a critical residue conferring nickel block to Ca(v)3.2 PMID: 16377633
- inhibitory effects of amiodarone on the modified T-type Cav3.2 Ca2+ channel created by long-term amiodarone treatment PMID: 16443692
- The expression of CACNA1H in breast cancer has been confirmed by RT-PCR. PMID: 16475676
- Linkage analysis of 44 pedigrees provided no evidence for a locus in the CACNA1H region; no Chinese variants were found in 220 unrelated patients. PMID: 16504478
- CACNA1H RNA is alternatively spliced at 12-14 sites where it can destroy, create or change the regulatory specificity of predicted exonic splicing enhancer sequences that may control splicing regulation. PMID: 16565161
- functional analysis shows that missense mutations significantly reduce Ca(V)3.2 channel activity and thus could affect neuronal function and potentially brain development and could contribute to the development of the ASD phenotype PMID: 16754686
顯示更多
收起更多
-
相關(guān)疾病:Epilepsy, idiopathic generalized 6 (EIG6); Epilepsy, childhood absence 6 (ECA6); Hyperaldosteronism, familial, 4 (HALD4)
-
亞細胞定位:Cell membrane; Multi-pass membrane protein.
-
蛋白家族:Calcium channel alpha-1 subunit (TC 1.A.1.11) family, CACNA1H subfamily
-
組織特異性:Expressed in the adrenal glomerulosa (at protein level). In nonneuronal tissues, the highest expression levels are found in the kidney, liver, and heart. In the brain, most abundant in the amygdala, caudate nucleus, and putamen. In the heart, expressed in
-
數(shù)據(jù)庫鏈接:
Most popular with customers
-
-
YWHAB Recombinant Monoclonal Antibody
Applications: ELISA, WB, IHC, IF, FC
Species Reactivity: Human, Mouse, Rat
-
Phospho-YAP1 (S127) Recombinant Monoclonal Antibody
Applications: ELISA, WB, IHC
Species Reactivity: Human
-
-
-
-
-